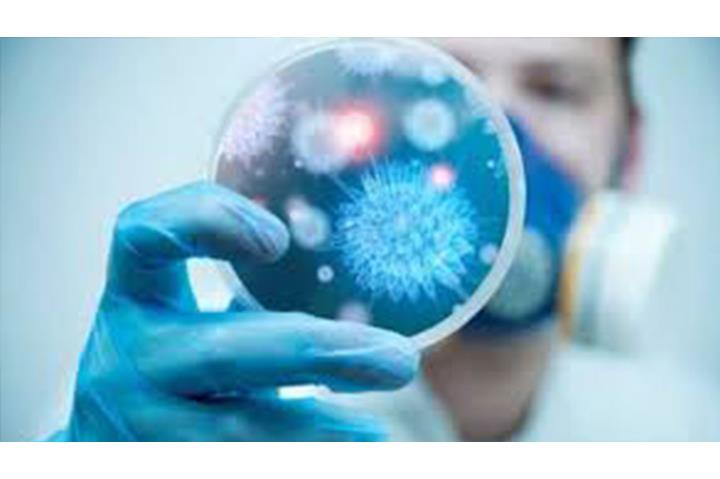

إذا كان لديك مسن عزيز عليك .. إليك طرق رعايته في زمن كورونا

بقلم |
ناهد إمام |
الخميس 02 ابريل 2020 - 10:22 م
"كبار السن"، تلك الفئة الغالية التي قضت العمر في الرعاية الأسرية، والعطاء بلا نهاية، حتى بلغوا من العمر أرذله، وأصبحوا في مرحلة "من بعد قوة ضعف وشيبة"، وأصبح وباء كورونا يشكل خطورة كبيرة عليهم.
وبيقى السؤال المهم: كيف نحمي الآباء والأمهات والأجداد من كورونا برفع مناعتهم؟!
هناك 5 اجراءات يومية لابد من اتباعها مع المسنين لتقوية جهاز المناعة لديهم، وهي كالتالي:
أولًا: العناية بالنظافة الشخصية
لاشك أن تعرض الجسم للجراثيم والميكروبات يؤثر سلبًا على جهاز المناعة، لذا لابد من الاهتمام باستحمام المسن، ونظافته الشخصية لدى دخوله لقضاء الحاجة، وغسل اليدين قبل وبعد تناول الطعام، وكذلك الاهتمام بنظافة ملابس المسن، وفراشه، وغرفته، وأي مكان يتواجد به.
ثانيًا: الحرص على تغذية المسن بطعام صحي
في مرحلة الشيخوخة تكون أجهزة الجسم في مرحلة خاصة لا تحتمل الاضعاف أو الاستهتار بتناول طعام غير صحي أو غير مغذي أو يؤدي إلى أعراض غير صحية أو تفاقم أمراض المسن، لذا لابد من الاهتمام بطعام المسن، بتناول الحبوب الكاملة، والخضروات والفواكة واللحوم، واتباع وسائل الطهي الصحية، والابتعاد عن المقليات، والسكريات، والدهون، والطعام المملح كالمخللات.
ثالثًا: الابتعاد عن التدخين وأماكنه
يحتاج جسم المسن للرعاية والوقاية من كل السموم، ومنها تلك التي تتسرب إلى رئتيه عبر السجائر، فابتعاده عن التدخين إن كان مدخنًا أو أماكن المدخنين يعني حمايته من أكثر من 4000 مادة كيميائية ضارة، تضعف جهاز مناعته.
رابعًا: الابتعاد عن الضغوط النفسية
" الكورتيزول"، هو ذلك الهرمون الذي يفرزه الجسم عند الشعور بالضغط النفسي، والقلق، والتوتر، وهو كفلي وحده باضعاف جهاز المناعة، ومن ثم يصبح الجسم عرضة سهلة لالتقاط الفيروسات والاصابة بالامراض، فاحرص على اراحة المسن نفسيًا.
خامسًا: شرب كمية كافية من الماء
لا يوجد أفضل من الماء لترطيب الجسم، ومحاربة الجفاف الذي يضر بالمسن وأنسجة الجسم فيضعف المناعة ويسهل الاختراق للفيروسات، ويصعب عملية التخلص من السموم.
وبيقى السؤال المهم: كيف نحمي الآباء والأمهات والأجداد من كورونا برفع مناعتهم؟!
هناك 5 اجراءات يومية لابد من اتباعها مع المسنين لتقوية جهاز المناعة لديهم، وهي كالتالي:
أولًا: العناية بالنظافة الشخصية
لاشك أن تعرض الجسم للجراثيم والميكروبات يؤثر سلبًا على جهاز المناعة، لذا لابد من الاهتمام باستحمام المسن، ونظافته الشخصية لدى دخوله لقضاء الحاجة، وغسل اليدين قبل وبعد تناول الطعام، وكذلك الاهتمام بنظافة ملابس المسن، وفراشه، وغرفته، وأي مكان يتواجد به.
ثانيًا: الحرص على تغذية المسن بطعام صحي
في مرحلة الشيخوخة تكون أجهزة الجسم في مرحلة خاصة لا تحتمل الاضعاف أو الاستهتار بتناول طعام غير صحي أو غير مغذي أو يؤدي إلى أعراض غير صحية أو تفاقم أمراض المسن، لذا لابد من الاهتمام بطعام المسن، بتناول الحبوب الكاملة، والخضروات والفواكة واللحوم، واتباع وسائل الطهي الصحية، والابتعاد عن المقليات، والسكريات، والدهون، والطعام المملح كالمخللات.
اقرأ أيضا:
حين تُسرق اللحظات: كيف نُعيد ضبط علاقتنا بالهواتف المحمولة؟ثالثًا: الابتعاد عن التدخين وأماكنه
يحتاج جسم المسن للرعاية والوقاية من كل السموم، ومنها تلك التي تتسرب إلى رئتيه عبر السجائر، فابتعاده عن التدخين إن كان مدخنًا أو أماكن المدخنين يعني حمايته من أكثر من 4000 مادة كيميائية ضارة، تضعف جهاز مناعته.
رابعًا: الابتعاد عن الضغوط النفسية
" الكورتيزول"، هو ذلك الهرمون الذي يفرزه الجسم عند الشعور بالضغط النفسي، والقلق، والتوتر، وهو كفلي وحده باضعاف جهاز المناعة، ومن ثم يصبح الجسم عرضة سهلة لالتقاط الفيروسات والاصابة بالامراض، فاحرص على اراحة المسن نفسيًا.
اقرأ أيضا:
بعد تجربة حب فاشلة أخشى الوحدة وعدم الزواج .. ماذا أفعل؟خامسًا: شرب كمية كافية من الماء
لا يوجد أفضل من الماء لترطيب الجسم، ومحاربة الجفاف الذي يضر بالمسن وأنسجة الجسم فيضعف المناعة ويسهل الاختراق للفيروسات، ويصعب عملية التخلص من السموم.